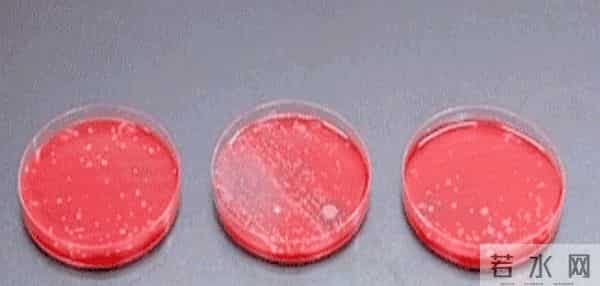
冲厕时一定要“盖上马桶盖”！小心在这3个地方“养细菌”

冲厕时一定要“盖上马桶盖”!小心在这3个地方“养细菌”
每个人都习惯在洗手间冲完马桶后立刻离开,可这一个习惯竟然可能让你和家人陷入严重健康隐患。
最新研究表明,当你不盖马桶盖冲水时,那些看不见的细菌和病毒会像无形的子弹一样,被气溶胶带着四散飞扬,落在家里的每个角落。
简单的动作,就可能成为家里各种细菌传播的重要渠道,值得你我都重视起这个细节。

科学家用特殊激光设备进行观察,发现冲水时产生的气溶胶颗粒能悬浮在空气中长达30分钟以上。
这些微粒能飞到1.5米范围内,恰好覆盖了大部分家庭卫生间的牙刷、毛巾、洗漱用品区域。

更让人震惊的是,在抽检的100个家庭中,有23%的马桶检测出了耐药性超级细菌MRSA。
这个数字不算小,意味着我们每个人家中可能都藏有一些“看不见的敌人”,而这些敌人正通过你我日常习惯默默扩散。
你是否还在习惯性“随手一冲”后离开?

其实,这是在用最简单的方式,把致病菌散布到空气中。
许多人不知道,马桶盖不仅仅是“装饰”,更是保护家人健康的重要屏障。

盖上马桶盖冲水,就像戴口罩一样,能有效减少气溶胶的传播。
但似乎很多人都忽略了这个小细节,或者觉得麻烦。
值得一提的是,这些气溶胶带有的细菌,有些还是耐药性超级细菌。

这意味着普通抗生素都难以根除,一旦有人感染,可能面临医生束手无策的局面。
这种风险,远比我们想象的要大得多。

你会不会觉得“只是洗个澡、冲个厕所,没想到竟然成了隐形杀手的传导源”?
除了用马桶盖,我们还能做什么?
其实生活中一点点小改变,就能很好守护家人健康。

比如,冲完马桶后立即洗手,别用手直接触碰马桶盖;牙刷一定要放在带门的柜子里,不让空气中的细菌飘到牙刷上;毛巾每周用高温(60℃以上)清洗,也能大大降低细菌滋生的风险;还有,定期用含氯消毒剂擦洗马桶周边,形成死角也要杀菌。
更别说很多人习惯带手机进入卫生间,这个习惯要彻底改一改。

调查发现,手机表面沾染马桶细菌的概率高达75%,比马桶座圈还脏。
每次用手机,可能都在无意中“收集”地狱的细菌,然后携带出门,带到办公室,带到餐厅。
这件事听起来令人毛骨悚然,但真切存在,不能忽视。

其实,卫生间的隐患,远不止藏在那些看不到的“微粒”里,更在于我们的那些细节习惯。
忽视了基本防护措施,就等于把家人健康置于危险之中。

养成盖马桶盖的习惯,虽然简单,却像戴口罩一样重要。
它可能不如洗手、洗澡那么明显,但每次都坚持,能有效减少很多不必要的健康隐患。
再说,最令人担忧的还是耐药菌的扩散。

我们当下可能习以为常,却不知道,这些超级细菌一旦传播开来,无药可医的局面将更严重。
里都在和这些细菌作战,家庭中没想到也可能成为战场。

这不是危言耸听,科学数据显示,有的家庭检测出耐药菌的比例还在不断上升。
如果你还停留在“冲一下就行”的心里,最好重新考虑,做出一些改变。
把概念牢牢记在心中:冲马桶,必须盖上盖子;卫生用品要定期用热水消毒;手机、毛巾这样每天都要触碰到的东西,也要注意消毒。
这样小小的细节,能为你和家人的健康筑起一道坚固的防线。
同时,这也提醒我们别再掉以轻心。

家庭卫生,不只是洗洗澡、整理一下那么简单,而是需要警觉和行动。
一个细节,一个习惯,都关系到家人的安危。
所有的安全措施看似琐碎,却是抗击隐形杀手的最前线。

不要等到出现问题时才后悔,养成保护自己和家人的习惯,从每一个冲厕所的瞬间开始。
总而言之,这个看似不起眼的小细节,竟然隐藏着巨大的健康风险。
只要记住:盖上马桶盖,勤洗手,避免带手机进入卫生间,保持用品高温清洗,日常坚持,就能大大降低细菌、病毒甚至超级细菌带来的威胁。
给家人多一点关心,少一点疏忽,健康就会离我们更近一步。
现在就行动起来,不然你可能会为下一次突发的感染付出更大的代价。
本文标题:冲厕时一定要“盖上马桶盖”!小心在这3个地方“养细菌”
本文链接:http://www.hniuzsjy.cn/hangye/40095.html
声明:本站所有文章资源内容,如无特殊说明或标注,均为采集网络资源。如若本站内容侵犯了原著者的合法权益,可联系本站删除。




